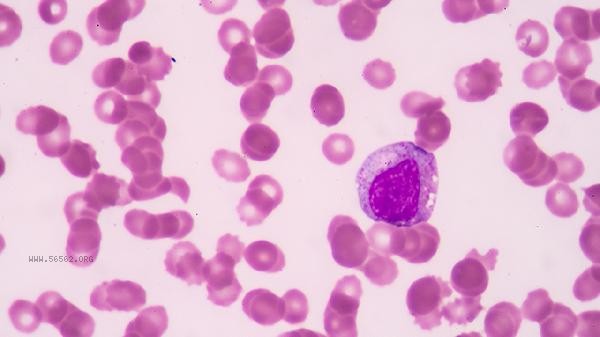

The five-year survival rate of non-small cell lung cancer is about 25% -30%, and the actual cure rate is closely related to stage, pathological type, gene mutation status, treatment plan, and patient constitution.
1. Staging effect:
The five-year survival rate of early stage I patients after surgery can reach 60% -80%, while the five-year survival rate of locally advanced stage III patients through comprehensive treatment is about 15% -30%. However, the five-year survival rate of late stage IV patients is less than 5%. When the diameter of the tumor is less than 3 centimeters and there is no lymph node metastasis, radical surgery has the best effect.
2. Pathological type:
Adenocarcinoma is sensitive to targeted therapy, and patients with EGFR mutations can have a median survival of 2-3 years using drugs such as gefitinib; Squamous cell carcinoma relies more on radiotherapy and chemotherapy, and the effective rate of immunotherapy for PD-L1 high expression patients is about 30%. Large cell carcinoma has a higher degree of malignancy and a relatively poor prognosis.
3. Genetic testing:

Individuals with driver gene mutations such as EGFR/ALK/ROS1 can extend disease control time to 11-34 months with targeted drugs. Rare mutations such as MET amplification or RET fusion require individualized treatment plans, and patients with high levels of TMB are more likely to benefit from immunotherapy.
4. Comprehensive treatment:
surgery combined with adjuvant chemotherapy can reduce the risk of recurrence in stages IB-IIIA by 40%, and synchronous radiotherapy and chemotherapy can increase the three-year survival rate of unresectable stage III patients to 30%. The combination of anti angiogenic drug bevacizumab and chemotherapy can prolong late stage progression free survival.
5. Individual differences: Patients with a PS score of 0-1 have better tolerance, and those under 70 years old are more suitable for intensive treatment. Combining COPD or cardiovascular disease may limit treatment options, and nutritional status and immune function directly affect treatment outcomes. Regular low-dose CT screening can detect sub centimeter lesions early, and tumor markers and imaging should be rechecked every 3-6 months after surgery. A balanced diet ensures a daily intake of 60g of high-quality protein, and moderate exercise such as Tai Chi improves cardiovascular function. Avoid exposure to secondhand smoke and kitchen fumes. Patients with EGFR mutations should use estrogen containing health products with caution. psychological intervention can alleviate treatment anxiety, and pain management adopts the principle of step-by-step administration. Precision medicine guided by genetic testing is continuously improving long-term survival rates.

Comments (0)
Leave a Comment
No comments yet
Be the first to share your thoughts!